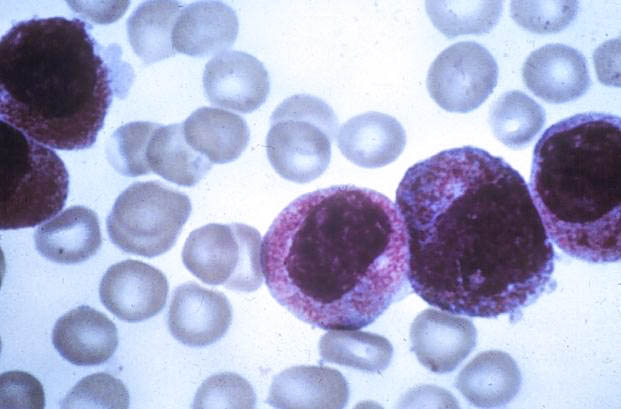
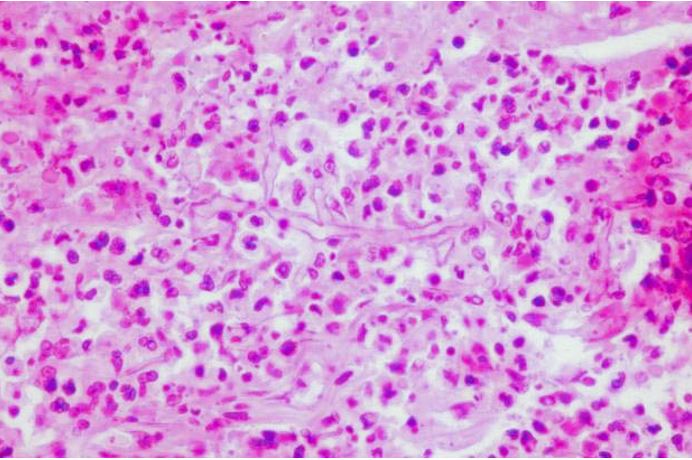

The following samples are available to demonstrate exam question format only.
Directions: All ABPath exam questions are multiple choice, single best answer. Choose the single best answer.
A pathologist was asked to assess the margins on a 3 x 1.5-cm skin specimen removed for suspected basal cell carcinoma. Separate frozen sections were performed on each of the four margins. What is the CPT coding for this intraoperative consultation?
A) 88305 x 4
B) 88331 x 4
C) 88331 x 1 and 88332 x 3
D) 88332 x 4
What is the major morphologic manifestation of chronic rejection of a lung allograft?
A) bronchiolitis obliterans
B) interstitial fibrosis
C) nonspecific interstitial pneumonitis
D) perivascular mononuclear infiltrates
What is the most frequent cause of primary hyperparathyroidism?
A) chronic renal disease
B) malabsorption syndrome
C) parathyroid adenoma
D) parathyroid carcinoma
E) primary parathyroid hyperplasia
A melanoma is most likely to arise in which type of nevus?
A) blue nevus
B) compound nevus in a fair-skinned, blue-eyed redhead
C) giant congenital nevus
D) pigmented spindle cell nevus
E) Spitz nevus
Directions: Choose the single best answer.
This biopsy specimen is from an 18-year-old male who underwent bone marrow transplantation for acute leukemia. What is the most likely diagnosis?
A) graft-versus-host disease
B) junctional nevus
C) leukemic infiltration
D) lymphoma cutis
E) mycosis fungoides

What is the best interpretation for this cervicovaginal cytology specimen from a 32-year-old patient?
A) negative for intraepithelial lesion or malignancy
B) reactive cellular changes associated with inflammation
C) atypical squamous cells of undetermined significance
D) low-grade squamous intraepithelial lesion
E) high-grade squamous intraepithelial lesion

What are these GMS-stained organisms?
A) Blastomyces dermatitidis
B) Cryptococcus neoformans
C) Pneumocystis jiroveci
D) trophozoites of Entamoeba histolytica
E) yeasts of Candida species

What is the most likely diagnosis for this 4-cm tumor from the neck of a 51-year-old male?
A) carotid body tumor
B) granular cell tumor
C) malignant melanoma
D) metastatic renal carcinoma
E) mucoepidermoid carcinoma

What is the most likely diagnosis for this section of patient kidney biopsy stained with anti-IgG?
A) acute post streptococcal glomerulonephritis
B) Goodpasture syndrome
C) minimal-change disease
D) systemic lupus erythematosus
E) granulomatosis with polyangiitis

What is the most likely diagnosis for this brain lesion?
A) arteriovenous malformation
B) glioblastoma multiforme
C) infarction
D) pilocytic astrocytoma
E) radiation necrosis

This PAS-stained section of a 3-cm nodule is from the parotid gland of a 45-year-old female. What is the most likely diagnosis?
A) acinic cell carcinoma
B) adenoid cystic carcinoma
C) normal parotid tissue
D) pleomorphic adenoma
E) Warthin tumor

What is the most likely diagnosis for this needle core biopsy from the breast of a 52-year-old female?
A) chronic mastitis
B) fat necrosis
C) invasive lobular carcinoma
D) metastatic small cell carcinoma
E) myeloma

This photograph is of the driver of a car that overturned and caught fire after a head-on collision. What is the most likely cause of these injuries?
A) falling on gravel
B) postmortem burns caused by gasoline
C) second-degree burns caused by heat
D) steering-wheel impact
E) the body’s dragging on the ground

Directions: Choose the one answer that is best in each case.
A 77-year-old male with severe peripheral vascular disease presented with severe abdominal pain of several hours’ duration. There was no history of trauma or chest pain. Laboratory studies included the following:
| Test (units) | Patient Result | Reference Range |
| Total creatine kinase (CK) (IU/L) | 275 | 21-232 |
| CK-MB (ng/mL) | 3 | 0-5 |
What is the most likely source of the elevated CK activity?
A) hepatic congestion
B) infarcted bowel
C) myocardial infarction
D) renal infarction
E) rhabdomyolysis
Which myelodysplastic syndrome is most likely to transform to acute leukemia?
A) chronic myelomonocytic leukemia
B) refractory anemia
C) refractory anemia with excess blasts
D) refractory anemia with ringed sideroblasts
E) refractory thrombocytopenia
A patient with recurrent episodes of venous and arterial thrombosis received therapeutic doses of heparin, but the heparin failed to exert an anticoagulant effect. The patient most likely has a deficiency of which of the following?
A) antithrombin
B) factor VIII
C) plasminogen
D) platelets
E) protein C
What is the most common type of allogeneic transfusion reaction from packed red blood cells?
A) acute hemolytic
B) allergic
C) delayed hemolytic
D) febrile, nonhemolytic
E) transfusion-related acute lung injury
What is the most common cause of fatal hemolytic transfusion reactions?
A) clerical errors related to misidentification of patients
B) emergency transfusion of uncrossmatched blood
C) excessively rapid transfusion of red blood cells
D) failure to premedicate patients with acetaminophen
E) laboratory technical or testing mistakes
A 55-year-old female presented with pulmonary necrotizing granulomatous inflammation, cutaneous leukocytoclastic angiitis, and necrotizing crescentic glomerulonephritis. She would most likely test positive for which of the following?
A) anti-neutrophil cytoplasmic antibodies
B) anti-nuclear antibodies
C) anti-phospholipid antibodies
D) hepatitis C virus antibodies
E) IgA fibronectin aggregates
Which oncogene becomes activated in the t(14;18) that is often associated with follicular lymphoma?
A) Bcl-2
B) Bcr/abl
C) Ets-1
D) Myc
E) Mos
A blood agar plate had small, nonhemolytic colonies isolated from an intra-abdominal abscess. The isolate was catalase negative, bile esculin positive, and pyrrolidonyl arylamidase (PYR) positive, and grew in 6.5% sodium chloride. What is the most likely identification?
A) Enterococcus species
B) group B Streptococcus
C) Pneumococcus
D) Staphylococcus species
The acquired B phenomenon is associated with antigens from which organism?
A) Candida albicans
B) Escherichia coli O86
C) Legionella pneumophila
D) Mycoplasma pneumoniae
E) Treponema pallidum
The concentration of an analyte was measured in nondiseased and diseased populations, and cutoff point Q was chosen. The number of false-positive results is represented by which area?
A) W
B) X
C) Y
D) Z

This flow cytometric dot plot of peripheral blood lymphocytes stained for CD3 and CD8 is from a patient with a decreased absolute number of lymphocytes. What is the most likely diagnosis?
A) AIDS
B) cytomegalovirus infection
C) infectious mononucleosis
D) no pathologic change
E) T-cell large granular lymphocytic leukemia

What is the most likely diagnosis for this blood film from a 38-year-old female?
A) acute myeloid leukemia with inv(16)(p13q22)
B) acute myeloid leukemia with maturation
C) acute myelomonocytic leukemia
D) acute promyelocytic leukemia
E) mast cell leukemia
The appearance of the hand suggests that this infant has which of these disorders?
A) a chromosomal abnormality
B) a cleft lip and palate
C) a short fourth metacarpal
D) holoprosencephaly
E) rocker-bottom feet

These data are serum electrophoresis and immunofixation from an 85-year-old female. What is the best interpretation?
A) acute-phase reactant pattern
B) IgA monoclonal gammopathy
C) normal study
D) Waldenström macroglobulinemia

What is the most likely diagnosis for this bile duct brush cytology from a 45-year-old female?
A) amoebae
B) Cryptosporidium
C) degenerated epithelial cells
D) Giardia
E) normal epithelial cells

This subcutaneous tissue biopsy is from a patient who sustained a firecracker injury. What is the most likely diagnosis?
A) aspergillosis
B) botryomycosis
C) phaeohyphomycosis
D) sporotrichosis
E) zygomycosis